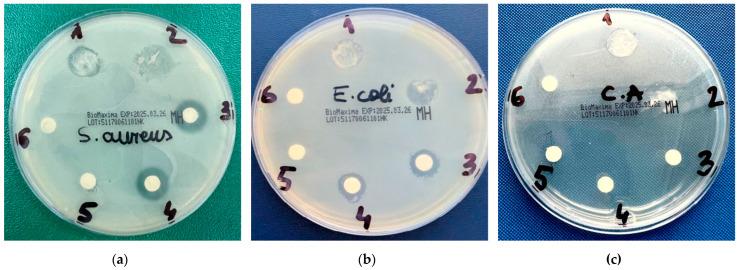
https://cdn.ncbi.nlm.nih.gov/pmc/blobs/c25e/11765333/dfd2843580be/gels-11-00061-g011.jpg

含迷迭香精油的温敏凝胶:一种用于抗菌治疗和药物递送应用的新型局部载体。
Thermoresponsive Gels with Rosemary Essential Oil: A Novel Topical Carrier for Antimicrobial Therapy and Drug Delivery Applications.
作者信息
Bejenaru Ludovic Everard, Segneanu Adina-Elena, Bejenaru Cornelia, Bradu Ionela Amalia, Vlase Titus, Herea Dumitru-Daniel, Văruţ Marius Ciprian, Bălăşoiu Roxana Maria, Biţă Andrei, Radu Antonia, Mogoşanu George Dan, Ciocîlteu Maria Viorica
机构信息
Department of Pharmacognosy & Phytotherapy, Faculty of Pharmacy, University of Medicine and Pharmacy of Craiova, 2 Petru Rareş Street, 200349 Craiova, Romania.
Institute for Advanced Environmental Research, West University of Timişoara, 4 Oituz Street, 300086 Timişoara, Romania.
出版信息
Gels. 2025 Jan 12;11(1):61. doi: 10.3390/gels11010061.
This study investigates the development and comprehensive characterization of innovative thermoresponsive gels incorporating rosemary essential oil (RoEO) encapsulated in poly(lactic--glycolic acid) (PLGA) microparticles, with a focus on their potential applications in topical antimicrobial and wound healing therapies. RoEO, renowned for its robust antimicrobial, antioxidant, and wound-healing properties, was subjected to detailed chemical profiling using gas chromatography-mass spectrometry (GC-MS), which identified oxygenated monoterpenes as its dominant constituents. PLGA microparticles were synthesized through an optimized oil-in-water emulsion technique, ensuring high encapsulation efficiency and structural integrity. These microparticles were thoroughly characterized using Fourier-transform infrared (FTIR) spectroscopy to confirm functional group interactions, scanning electron microscopy (SEM) for surface morphology, X-ray diffraction (XRD) for crystalline properties, and thermal analysis for stability assessment. The synthesized microparticles displayed uniform size distribution and efficient encapsulation, demonstrating compatibility with the gel matrix. Two distinct thermoresponsive gel formulations were developed using varying ratios of Poloxamer 407 and Poloxamer 188 to achieve optimal performance. The gels were evaluated for key physicochemical properties, including pH, gelation temperature, viscosity, and rheological behavior. Both formulations exhibited thermoresponsive gelation at skin-compatible temperatures (27.6 °C and 32.9 °C), favorable pH levels (6.63 and 6.40), and shear-thinning behavior suitable for topical application. Antimicrobial efficacy was assessed against common pathogens associated with skin infections, including , , and . The RoEO-PLGA-loaded gels demonstrated significant inhibitory effects, confirming their potential as effective carriers for controlled and localized drug delivery. These findings underscore the promising application of RoEO-PLGA-loaded thermoresponsive gels in addressing challenges associated with topical antimicrobial therapies and wound care, offering an innovative approach to enhancing therapeutic outcomes. By integrating the bioactive potential of RoEO with the advanced delivery capabilities of PLGA microparticles and thermoresponsive gels, this study paves the way for the development of next-generation formulations tailored to meet the specific needs of localized drug delivery in skin health management.
本研究调查了包含包裹在聚乳酸-乙醇酸共聚物(PLGA)微粒中的迷迭香叶精油(RoEO)的新型热敏凝胶的开发与全面表征,重点关注其在局部抗菌和伤口愈合治疗中的潜在应用。RoEO以其强大的抗菌、抗氧化和伤口愈合特性而闻名,使用气相色谱-质谱联用仪(GC-MS)对其进行了详细的化学分析,确定氧化单萜为其主要成分。通过优化的水包油乳液技术合成了PLGA微粒,确保了高包封率和结构完整性。使用傅里叶变换红外(FTIR)光谱确认官能团相互作用、扫描电子显微镜(SEM)观察表面形态、X射线衍射(XRD)分析晶体性质以及热分析评估稳定性,对这些微粒进行了全面表征。合成的微粒显示出均匀的尺寸分布和高效的包封,证明与凝胶基质具有相容性。使用不同比例的泊洛沙姆407和泊洛沙姆188开发了两种不同的热敏凝胶配方,以实现最佳性能。对凝胶的关键物理化学性质进行了评估,包括pH值、凝胶化温度、粘度和流变行为。两种配方在皮肤相容温度(27.6℃和32.9℃)下均表现出热敏凝胶化,具有适宜的pH值(6.63和6.40)以及适合局部应用的剪切变稀行为。评估了对与皮肤感染相关的常见病原体(包括 、 和 )的抗菌效果。负载RoEO-PLGA的凝胶显示出显著的抑制作用,证实了它们作为可控和局部药物递送有效载体的潜力。这些发现强调了负载RoEO-PLGA的热敏凝胶在应对局部抗菌治疗和伤口护理相关挑战方面的应用前景,为提高治疗效果提供了一种创新方法。通过将RoEO的生物活性潜力与PLGA微粒和热敏凝胶的先进递送能力相结合,本研究为开发满足皮肤健康管理中局部药物递送特定需求的下一代配方铺平了道路。